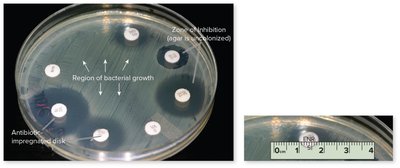
Kirby–Bauer disc diffusion test
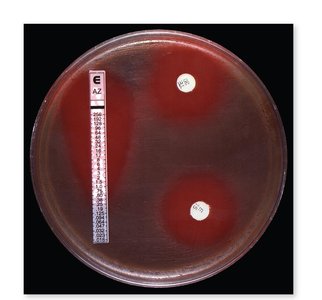
Etest for antimicrobial susceptibility

Back
BackChapter 12: Antimicrobial Treatment – Principles, Drug Groups, and Resistance
Study Guide - Smart Notes

Antimicrobial Treatment: Principles and Practice
Principles of Antimicrobial Therapy
The main goal of antimicrobial treatment is to destroy the infective agent without harming the host’s cells. The ideal antimicrobial drug would be toxic to the microbe but nontoxic to the host, microbicidal rather than microbiostatic, soluble in body fluids, and remain potent long enough to act. However, no drug is perfect, and resistance or adverse effects may occur.
Selective toxicity: Drugs should target microbial cells without damaging host tissues.
Therapeutic index (TI): The ratio of the dose toxic to humans to the effective dose. A higher TI indicates a safer drug.
Antimicrobial susceptibility testing: Methods include the Kirby–Bauer disc diffusion test, Etest, and tube dilution tests to determine the minimum inhibitory concentration (MIC).

Key terminology:
Prophylaxis: Use of a drug to prevent infection.
Antimicrobials: Any drug targeting microorganisms.
Antibiotics: Drugs produced by microorganisms or synthesized to inhibit bacteria.
Synthetic/Semisynthetic drugs: Chemically modified or fully synthesized drugs.
Narrow-spectrum: Effective against a limited array of microbes.
Broad-spectrum: Effective against a wide variety of microbes.
Origins of Antimicrobial Drugs
Many antibiotics are metabolic products of bacteria and fungi, such as Streptomyces. These organisms produce antibiotics to reduce competition in their environment.

Mechanisms of Drug Action
Antimicrobial drugs target five major sites in microbes:
Cell wall synthesis
Nucleic acid structure and function
Protein synthesis (ribosomes)
Cell membrane structure/function
Folic acid synthesis

Adverse Effects of Antimicrobials
Adverse reactions include toxicity to organs, allergic responses, and disruption of normal microbiota, leading to superinfections such as Candida albicans or Clostridioides difficile overgrowth.

Survey of Major Antimicrobial Drug Groups
Spectrum of Activity
Broad-spectrum drugs (e.g., tetracyclines) act against multiple groups of bacteria, while narrow-spectrum drugs (e.g., penicillin) target specific groups.

Cell Wall Inhibitors
β-Lactam antibiotics (penicillins, cephalosporins, carbapenems) inhibit cell wall synthesis. Penicillins consist of a thiazolidine ring, β-lactam ring, and variable side chain. Resistance can occur via β-lactamase enzymes.


Protein Synthesis Inhibitors
Aminoglycosides, tetracyclines, macrolides, streptogramins, oxazolidinones, and pleuromutilins inhibit protein synthesis by targeting bacterial ribosomes.



Folic Acid Synthesis Inhibitors
Sulfonamides (sulfa drugs) block enzymes required for folic acid synthesis, affecting DNA, RNA, and amino acid production.


DNA/RNA Synthesis Inhibitors
Fluoroquinolones inhibit DNA unwinding enzymes (helicases), stopping transcription. Rifampin is used for gram-positive rods and tuberculosis.

Cell Membrane Disruptors
Polymyxins and daptomycin interact with membrane phospholipids, causing leakage and cell death, especially in gram-negative bacteria.
Biofilm Treatment
Biofilm bacteria are less sensitive to antimicrobials. Treatment strategies include interrupting quorum-sensing pathways and using drugs like daptomycin.
Antifungal, Antiprotozoal, and Antihelminthic Agents
Antifungal drugs include macrolide polyenes, azoles, echinocandins, and allylamines. Antiprotozoal drugs (e.g., metronidazole) and antihelminthics (e.g., albendazole, pyrantel) target specific parasites.
Antiviral Agents
Antiviral drugs act by barring viral entry, blocking replication/transcription/translation, or preventing viral assembly/release.




Antimicrobial Resistance
Acquisition of Resistance
Microbes acquire resistance through spontaneous mutation or horizontal gene transfer (conjugation, transformation, transduction). Resistance mechanisms include:
Synthesis of new enzymes (e.g., penicillinase)
Decreased permeability or uptake of the drug
Immediate elimination of the drug (active efflux)
Decreased number or affinity of drug binding sites
Alternative metabolic pathways


Natural Selection and Human Role
Drug-resistant microbes survive and proliferate when exposed to antibiotics. Overuse and misuse in medicine, hospitals, and animal feeds accelerate resistance.


New Approaches and Probiotics
Novel strategies include nanomaterials, antisense RNAs, CRISPR, bacteriophages, and targeting gram-negative membrane proteins. Probiotics, prebiotics, and fecal transplants help restore healthy microbiota.


Summary Table: Major Drug Groups and Their Targets
Drug Group | Target | Example |
|---|---|---|
Cell Wall Inhibitors | Peptidoglycan synthesis | Penicillin, Cephalosporin |
Protein Synthesis Inhibitors | Ribosomes | Streptomycin, Tetracycline, Erythromycin |
Folic Acid Synthesis Inhibitors | Enzymes for folic acid | Sulfonamides |
DNA/RNA Synthesis Inhibitors | DNA/RNA polymerases | Fluoroquinolones, Rifampin |
Cell Membrane Disruptors | Membrane phospholipids | Polymyxin |
Additional info: These notes expand on brief points with academic context, definitions, and examples to ensure completeness and clarity for exam preparation.
